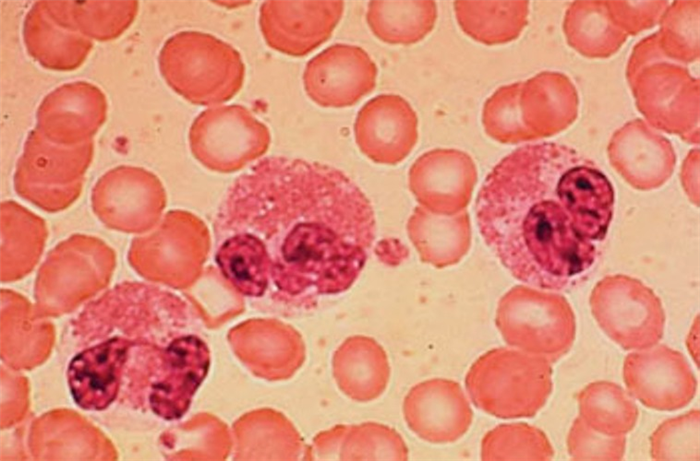

Легочная эозинофилия. Причины и классификация легочной эозинофилии
Добавил пользователь Евгений Кузнецов Обновлено: 24.10.2025
Эозинофилия на КТ легких: причины, диагностика
а) Терминология:
1. Синонимы:
• Простая легочная эозинофилия (ПЛЭ): синдром Леффлера
• Эозинофильный гранулематоз с полиангиитом (ЭГПА): синдром Черджа-Стросса (термин больше не применяется)
2. Определение:
• Группа заболеваний легких, ассоциированных с нижеперечисленными состояниями:
о Периферическая эозинофилия крови или тканевая эозинофилия
о Увеличение количества эозинофилов в жидкости, полученной при бронхоальвеолярном лаваже (БАЛ)
3. Классификация:
• Идиопатические эозинофильные пневмонии:
о ПЛЭ
о Острая эозинофильная пневмония (ОЭП)
о Хроническая эозинофильная пневмония (ХЭП)
о Синдром идиопатической гиперэозинофилии (СИГ)
• Эозинофильные пневмонии известной этиологии:
о Аллергический бронхолегочный аспергиллез (АБЛА)
о Бронхоцентрический гранулематоз(БГ)
о Эозинофильная пневмония, обусловленная реакцией на лекарственный препарат или паразитарную инвазию
• Эозинофильный васкулит:
о ЭГПА
• Заболевания, в отдельных случаях связанные с эозинофильной инфильтрацией:
о Идиопатический легочный фиброз, саркоидоз, криптогенная организующаяся пневмония (КОП), гиперчувствительный пневмонит
б) Визуализация:
1. Рентгенологическая картина эозинофильных заболеваний:
• ПЛЭ:
о Субсегментарные затемнения:
- Периферические, одно- или двухсторонние, преходящие или мигрирующие, обычно разрешающиеся в течение одного месяца
• ОЭП:
о Имитирует кардиогенный отек легких; сердце не увеличено
о Наиболее ранние изменения: септальные линии и ретикулярные изменения
о Быстро прогрессируете появлением обширных участков «матового стекла» и сливных участков консолидации
о Минимальный двухсторонний плевральный выпот
• ХЭП:
о Двухсторонние несегментарные симметричные участки консолидации с преимущественной локализацией в наружных отделах и верхних долях легких: «фотографический негатив отека легких»
• СИГ:
о Очаговые или диффузные, ретикулярные или однородные субсегментарные затемнения
о Плевральный выпот (<50%)
• АБЛА:
о Центральные бронхоэктазы: расширение центральных бронхов, симптом «трамвайных рельсов», кольцевидные тени:
- Слизистые пробки: симптом «пальцев в перчатке» или затемнения вытянутой формы
• БГ:
о Очаги или объемные образования (60%) и участки консолидации (27%)
• Эозинофильная пневмония, обусловленная реакцией на лекарственный препарат:
о Участки консолидации и «матового стекла» с преимущественной локализацией в верхних периферических отделах легких
• Эозинофильная пневмония, обусловленная паразитарной инвазией:
о Разбросанные участки консолидации, которые могут сливаться в более тяжелых случаях, например, при стронгилоидозе
• ЭГПА:
о Двусторонние несегментарные участки консолидации:
- Транзиторные, преимущественно периферические
о Ретикулярные или ретикулонодулярные изменения
о Одно- или двусторонний плевральный выпот

(Слева) На аксиальной КТ без КУ у женщины 61 года с острой идиопатической эозинофильной пневмонией определяются диффузные участки «матового стекла» на фоне утолщения междольковых перегородок и внутридольковых тяжей. Это т.н. картина «сумасшедшей исчерченности».
(Справа) На корональной КТ без КУ у этой же пациентки определяются диффузные двусторонние участки «матового стекла». Острая эозинофильная пневмония характеризуется быстрым возникновением дыхательной недостаточности, лихорадки и эозинофилии, и связана с недавним началом курения или вдыханием пыли во время терактов во Всемирном Торговом Центре.
2. КТ легких при эозинофилии:
• ПЛЭ:
о Одно- или двусторонние субсегментарные участки консолидации
о Разбросанные субплевральные очаги ± симптом «гало»
о Разбросанные участки «матового стекла»
о Полости в очагах и плевральный выпот отсутствуют
• ОЭП:
о «Матовое стекло» (100%), картина «сумасшедшей исчерченности», «мозаичная» картина
о Утолщение междольковых перегородок в отсутствие узлов (90%)
о Утолщение бронховаскулярных пучков (66%)
о Консолидация (55%)
о Центрилобулярные очаги с нечеткими границами (30%)
• ХЭП:
о Однородные участки консолидации с преимущественной локализацией в периферических отделах верхних долей
о «Матовое стекло» на фоне утолщения междольковых перегородок: картина «сумасшедшей исчерченности»
о Очаг или объемное образование (редко); может имитировать рак легкого
• СИГ:
о Отек легких, обусловленный сердечной недостаточностью:
- Равномерное утолщение междольковых перегородок, утолщение бронховаскулярных пучков
о Периферические очаги от нескольких миллиметров до сантиметра ± «матовое стекло» на периферии
о Солитарные или множественные участки «матового стекла» с периферическим распределением
• АБЛА:
о Центральные бронхоэктазы, более выраженные в верхних долях:
- Слизистые пробки высокой плотности (30%)
- Ателектаз или спадение легкого дистальнее зоны обструкции бронха
• БГ:
о Очаговое объемное образование или участок консолидации с ателектазом
• Эозинофильная пневмония, обусловленная реакцией на лекарственный препарат или паразитарной инвазией
о Консолидация, «матовое стекло», картина «сумасшедшей исчерченности»:
- Аскаридоз: мигрирующие участки «матового стекла»
- Стронгилоидоз: часто осложняется бактериальной пневмонией
о Преимущественное поражение периферических отделов верхних долей легких:
- Тропическая легочная эозинофилия:
Слабо выраженные ретикулонодулярные изменения в нижних отделах легких
• ЭГПА:
о Участки консолидации или «матового стекла»:
- Разбросанные, преимущественно периферические
о Утолщение стенок бронхов, бронхоэктазы, «дерево в почках»
о Утолщение междольковых перегородок
о Очаги >10 мм

(Слева) На корональной КТ без КУ (MIP) у мужчины 31 года с аллергическим бронхолегочным аспергиллезом и периферической эозинофилией определяются двухсторонние бронхоэктазы со слизистыми пробками в просвете. Некоторые из этих пробок имеют характерный вид «пальцев в перчатке».
(Справа) На корональной КТ без КУ у этого же пациента в язычковых сегментах левого легкого визуализируется гиперденсная слизистая пробка. Слизистые пробки обнаруживаются у 30% пациентов с аллергическим бронхолегочным аспергиллезом.
в) Дифференциальная диагностика поражения легких при эозинофилии:
1. Криптогенная организующаяся пневмония (КОП):
• Могут обнаруживаться лучевые проявления, идентичные ХЭП
• Рецидивирующие мигрирующие участки консолидации
• Симптом «обратного гало» (часто)
• Расширение бронхов чаще наблюдается при КОП
• Для КОП более характерны очаги и объемные образования
• Изменения обычно ассиметричные
2. Внебольничная пневмония:
• Симптомы: кашель, лихорадка, лейкоцитоз
• Положительная реакция на антибактериальную терапию
3. Кардиогенный отек легких:
• Кардиомегалия и плевральный выпот
• Гравитационно зависимые участки консолидации
• Равномерное утолщение междольковых перегородок

(Слева) На аксиальной КТВР у пациента с простой легочной эозинофилией, выполненной во время обострения заболевания (слева) и месяц спустя (справа), визуализируются разбросанные участки «матового стекла», впоследствии практически полностью разрешившиеся.
(Справа) На аксиальной КТ с КУ у мужчины 42 лет с синдромом идиопатической гиперэозинофилии, с жалобами на нарушение дыхания и эритематозную сыпь по всему телу, с персистирующей эозинофилией на протяжении восьми месяцев, визуализируются неспецифические диффузные участки «матового стекла» в обоих легких.
г) Клинические особенности:
1. Проявления:
• Типичные признаки/симптомы:
о ПЛЭ:
- Разрешается самостоятельно, обычно в течение 1-2 недель
- Реакция иммунной гиперчувствительности на Ascaris lumbricoides и другие виды паразитов
о ОЭП:
- Быстрое развитие дыхательной недостаточности, лихорадка (продолжительностью Прогрессирующая эозинофильная инфильтрация легких
- Причины: недавнее начало курения, «пассивное» курение, курение ароматизированных сигар, вдыхание пыли при терактах во Всемирном Торговом Центре
о ХЭП:
- Диспноэ, кашель, гипоксемия различной степени выраженности:
Эозинофилия крови и легких
- Часто страдают пациенты с астмой о СИГ:
- Эозинофилия крови > 1 500/мм 3 (>6 месяцев):
Эозинофилия жидкости, полученной при бронхоальвеолярном лаваже (до 73%)
- Полиорганное поражение:
Часто страдает сердце (застойная сердечная недостаточность)
Легочные проявления у (вплоть до) 40% пациентов
о АБЛА:
- Реакция гиперчувствительности на антигены Aspergillus, обычно Aspergillus fumigatus
о БГ:
- Комплексный ответ тканей на колонизацию дыхательных путей грибками:
Описательный патологический диагноз
- Часто сочетается с АБЛА
о Эозинофильная пневмония, обусловленная реакцией на лекарственный препарат:
- Обусловлена различными лекарствами и токсическими веществами:
Не всегда наблюдается связь с кумулятивной дозой или длительностью лечения
- Острое или подострое начало:
Симптоматика напоминает ПЛЭ или молниеносную форму ОЭП
Токсический эпидермальный некролиз, эозинофилия и системная симптоматика в ответ на воздействие лекарственного препарата (синдром DRESS); может становиться жизнеугрожающим состоянием
о Эозинофильная пневмония, обусловленная паразитарной инвазией:
- В различных географических областях могут наблюдаться разные типы паразитарной инвазии:
В зоне риска находятся путешественники, вернувшиеся из эндемичных районов
- A. lumbricoides: наиболее частая причина периферической эозинофилии крови и патологических изменений в легких
- Strongyloides stercoralis: может приводить к жизнеугрожающему синдрому гиперинфекции, чаще у пациентов с иммунодефицитом (например, длительное время принимающих кортикостероиды), часто осложняется бактериальной пневмонией
- Тропическая легочная эозинофилия:
Этиология: филярии Wuchereria bancrofti и Brugia malayi
БАЛ: высокий уровень IgE и IgG
о ЭГПА:
- Редкое системное заболевание у пациентов с астмой, проявляющееся лихорадкой, периферической гиперэо-зинофилией (>10%), преходящими или мигрирующими затемнениями в легких, поражением околоносовых пазух, внесосудистой эозинофилией при исследовании биоптата
2. Респираторная симптоматика:
• Легкая, самостоятельно разрешающаяся: ПЛЭ и СИГ
• Умеренно выраженная или тяжелая: ХЭП, АБЛА, ЭГПА
• Тяжелая: ОЭП
д) Диагностическая памятка:
1. Следует учесть:
• ЭГПА, АБЛА, БГ у пациентов с астмой
• Эозинофильную пневмонию, обусловленную паразитарной инвазией, у путешественников, вернувшихся из эндемичных регионов
• Эозинофильную пневмонию, обусловленную токсическим воздействием лекарств, при любом очаговом или диффузном патологическом процессе в легких
• ОЭП у пациентов с нормальными размерами сердца и гидростатическим отеком, не отвечающим на диуретики
2. Советы по интерпретации изображений:
• ХЭП может обусловливать симптом «фотографического негатива отека легких»
• АБЛА характеризуется центральными верхнедолевыми бронхоэктазами и гиперденсными слизистыми пробками
• ОЭП имитирует отек легких
Редактор: Искандер Милевски. Дата обновления публикации: 18.1.2022
Эозинофильная пневмония ( Легочная эозинофилия , Пневмония Лёффлера , Синдром Лера-Киндберга , Эозинофильный летучий инфильтрат легкого )
Эозинофильная пневмония – это аллерго-воспалительное поражение легочной ткани, сопровождающееся образованием неустойчивых мигрирующих инфильтратов эозинофильной природы и развитием гиперэозинофилии. Заболевание обычно протекает с недомоганием, субфебрилитетом, небольшим сухим кашлем, иногда со скудной мокротой; при острой форме - с болью в груди, миалгией, развитием острой дыхательной недостаточности. Установить эозинофильную пневмонию позволяют данные рентгенографии и КТ легких, общего анализа крови, бронхоальвеолярного лаважа, аллергопроб, серодиагностики. Основу лечения составляют специфическая гипосенсибилизация и гормональная терапия.
МКБ-10

Общие сведения
Эозинофильная пневмония (эозинофильный «летучий» инфильтрат легкого) - респираторное заболевание, связанное с патологическим накоплением эозинофилов в альвеолах и повышением их уровня в крови и мокроте. Эозинофильная пневмония чаще диагностируется у населения и туристов в странах с тропическим климатом (Индонезии, Индии, Малайзии, тропической Африке, Ю. Америке).
Эозинофильная пневмония протекает по типу долевой пневмонии или бронхопневмонии, затрагивает обычно верхние отделы легких. Отмечается очаговое или диффузное воспаление альвеол, интерстициальной ткани, сосудов, бронхиол с их обильной инфильтрацией эозинофилами. Типичен преходящий характер инфильтратов с полным регрессом без вторичных рубцовых и склеротических изменений тканей.
Выделяют 3 формы легочной эозинофилии - простую (пневмония Лёффлера), острую и хроническую (синдром Лера-Киндберга). На хронизацию процесса указывают длительное (>4 недель) сохранение и рецидивирование эозинофильных инфильтратов. Эозинофильной пневмонией одинаково часто болеют лица обоего пола, преимущественно в 16-40-летнем возрасте; хроническая форма чаще развивается у женщин, страдающих бронхиальной астмой.
Причины
Эозинофильное поражение легочной ткани инициируют патогены инфекционно-аллергической и аллергической природы, вызывающие сенсибилизацию организма пациента. В качестве них могут выступать:
- Паразитарная (глистная) инвазия. В 1932 г Лёффлер впервые определил роль гельминтов в этиологии эозинофильной пневмонии, возникающей при транзиторном повреждении легочной ткани в процессе миграции личинок паразитов через легкие. К появлению пневмонии Лёффлера может привести практически любой гельминтоз - аскаридоз, стронгилоидоз, шистосомоз, анкилостоматоз, парагонимоз, токсокароз, трихинеллез и др. Довольно часто при легочной эозинофилии выявляются нематоды Toxocara cati и T. canis, аскариды собак и кошек. Личинки и яйца глистов могут попадать в ткань легких с током крови, взрослые паразиты (Paragonimus westermani) - через кишечную стенку, диафрагму и плевру, вызывая эозинофильное воспаление с образованием инфильтратов.
- Ингаляционные и лекарственные аллергены. Эозинофильная пневмония может быть результатом аллергической реакции на прием медикаментов (пенициллина, ацетилсалициловой кислоты, сульфаниламидов, нитрофуранов, изониазида, гормональных и рентгенконтрастных препаратов, соединений золота), на контакт с химическими агентами на производстве (солями никеля), цветочной пыльцой (ландыша, лилии, липы). Пневмония Леффлера может быть проявлением сывороточной болезни, иметь связь с аллергией на туберкулин.
- Грибковая инфекция. Атопическая сенсибилизация дыхательного тракта к спорам грибов (особенно, рода Aspergillus) также способствует развитию эозинофильных легочных инфильтратов.
Патогенез
Развитие эозинофильной пневмонии опосредовано реакциями гиперчувствительности немедленного типа. Помимо гиперэозинофилии в крови пациентов часто выявляется повышенный уровень IgE (гипериммуноглобулинемия). За образование аллерго-воспалительных очагов в легочной ткани ответственны тучные клетки, активированные иммунными (IgE) и неиммунными (гистамином, системой комплемента) механизмами и продуцирующие медиаторы аллергии (главным образом, эозинофильный хемотаксический фактор анафилаксии). В ряде случаев эозинофильная пневмония развивается за счет выработки преципитирующих антител к антигенам (реакции по типу феномена Артюса).
Симптомы эозинофильной пневмонии
Клиническая картина бывает весьма вариабельной. Аллергическое воспаление легких может иметь бессимптомное течение с отсутствием или очень скудной выраженностью жалоб и определяться только рентгенологическим и клинико-лабораторным методом. Часто пневмония Лёффлера протекает с минимальными проявлениями, манифестируя симптомами катарального ринофарингита. Больные ощущают легкое недомогание, слабость, повышение температуры до субфебрильной, небольшой кашель, чаще сухой, иногда с незначительной вязкой или кровянистой мокротой, болезненность в области трахеи.
При массивном гематогенном распространении яиц и личинок глистов в организме присоединяется сыпь на коже, зуд, одышка с астматическим компонентом. Эозинофильная инфильтрация других органов сопровождается легкими, быстро исчезающими признаками их поражения – гепатомегалией, симптомами гастрита, панкреатита, энцефалита, моно- и полиневропатией.
Острая эозинофильная пневмония протекает тяжело, с интоксикацией, фебрилитетом, болью в груди, миалгией, быстрым (в течение 1-5 суток) развитием острой дыхательной недостаточности, респираторного дистресc-синдрома. Для хронической формы типично подострое течение с потливостью, потерей массы тела, нарастанием одышки, развитием плеврального выпота.
Эозинофильная пневмония обычно длится от нескольких дней до 2-4 недель. Выздоровление может наступать спонтанно. При хронической форме продолжительное существование инфильтратов и рецидивы способствуют постепенному прогрессированию заболевания, развитию легочного фиброза и дыхательной недостаточности.
Диагностика
Диагностика эозинофильной пневмонии включает проведение рентгенографии и КТ легких, общего анализа крови, анализа кала на яйца глист, бронхоальвеолярного лаважа, аллергопроб, серологических (РП, РСК, ИФА) и клеточных тестов (реакции дегрануляции базофилов и тучных клеток). Пациенты с эозинофильной пневмонией, как правило, имеют предшествующий аллергологический анамнез. Аускультация определяет небольшое количество влажных мелкопузырчатых хрипов или крепитацию. При обширных инфильтратах заметно укорочение легочного звука при перкуссии. Инструментально-лабораторный комплекс:
- Рентгенография легких. На снимках видны субплеврально расположенные одиночные (реже множественные, двусторонние) нечеткие затемнения средней интенсивности неправильной формы размером до 3-4 см. В окружении инфильтрата легочный рисунок усилен, тень корня легкого слегка расширена. Характерна быстрая динамика инфильтратов с миграцией по легочным полям и исчезновением не позднее 1-2 недель после обнаружения (чаще через 1-3 дня) без остаточной рубцовой деформации. При длительно поддерживающемся инфильтративном воспалении в ткани легких могут образоваться фиброзные очаги и кистозные полости.
- Лабораторные данные. В периферической крови на начальной стадии заболевания регистрируется лейкоцитоз, гиперэозинофилия (10-25%), при хронизации процесса уровень эозинофилов близок к норме. Часто выявляется высокое содержание в крови IgE (до 1000 МЕ/мл). В анализе лаважной жидкости также появляются эозинофилы (при острой форме – до 40% и более) и кристаллы Шарко-Лейдена. Анализ кала, проводимый с учетом цикла развития паразитов, при некоторых гельминтозах позволяет обнаружить яйца глист. По данным биопсии в альвеолах и интерстиции определяются эозинофилы, лимфоциты и макрофаги, гранулемы, поражение мелких сосудов.
- Аллергопробы. Этиологическая диагностика эозинофильной пневмонии включает провокационные назальные и ингаляционные тесты, кожные пробы с аллергенами пыльцы, гельминтов, спор грибов, серологические анализы. «Никелевая» эозинофильная пневмония обычно сочетается с аллергическим контактным дерматитом и подтверждается положительным компрессным (аппликационным) тестом с никелем.
- ФВД. Бронхиальную проходимость оценивают при проведении спирометрии, бронхомоторных тестов.
Дифференцировать эозинофильную пневмонию необходимо с пневмониями бактериального и вирусного генеза, туберкулезом, синдромом Вайнгартена, альвеолитом, десквамативным интерстициальным фиброзом. При атопической отягощенности показана консультация аллерголога, при респираторном рините - отоларинголога.
Лечение эозинофильной пневмонии
Основным в лечении является устранение действия этиологически значимого фактора: контакта с аллергенами (аэроаллергенами, лекарствами), проведение дегельминтизации. Назначаются антигистаминные препараты, противопаразитарные средства. Имеются случаи спонтанного выздоровления без фармакотерапии. В случае тяжелой глистной инвазии с обезвоживанием организма или невозможности полного изъятия аллергена из окружающей среды лечение проводится стационарно, в отделении пульмонологии.
При острой форме эозинофильной пневмонии применяются глюкокортикоиды, на фоне которых происходит быстрая (в течение 48 часов) регрессия воспаления. Дозу ГК подбирают индивидуально и снижают постепенно во избежание обострения. В тяжелых случаях требуются ИВЛ, длительная гормональная терапия. При бронхообструкции показаны ингаляционные ГК, бета-адреномиметики. Для лучшего отхождения мокроты используются отхаркивающие средства, дыхательная гимнастика. Проводится лечение сопутствующей бронхиальной астмы.
Прогноз и профилактика
Прогноз эозинофильной пневмонии в целом благоприятный, возможно самопроизвольное разрешение инфильтратов. Правильное лечение и наблюдение пульмонолога позволяет избежать хронизации процесса и рецидивов. Профилактика эозинофильной пневмонии сводится к мерам гигиены, предотвращающим заражение организма гельминтами, контролю за приемом медикаментов, ограничению контакта с аэроаллергенами, проведению специфической гипосенсибилизации. При необходимости рекомендуется смена места работы.
2. Легочные эозинофилии: диагностика, подходы к терапии/ Э.Х.Анаев, А.Г.Чучалин// Пульмонология. - 2012 -№ 4.
3. Эозинофильная пневмония в практике врача-терапевта: трудности диагностики/ Болдырева Л.Н., Пантелеева Е.Н.//Справочник поликлинического врача. - 2011 - №9.
4. Трудности этиологической диагностики легочной эозинофилии/ Николаева С.С., Растомпахова Т.А.// Сибирский медицинский журнал. - 2011.
Аспергиллез легких
Аспергиллёз лёгких – это заболевание грибковой этиологии, которое поражает все отделы дыхательной системы, протекает в острой или хронической форме, характеризуется разнообразием клинических симптомов, наличием признаков аллергии. Клиническая картина болезни включает кашель, кровохарканье, лихорадку и одышку. Диагноз устанавливается на основании рентгенографии и КТ органов грудной клетки, бронхоскопии, серологической диагностики, лабораторного исследования патологического материала. Назначается консервативное лечение фунгицидами, при необходимости в сочетании с антибиотиками и глюкокортикостероидами. Аспергилломы удаляются хирургическим путём.


Аспергиллёз лёгких по распространенности занимает первое место среди лёгочных микозов. 75% всех случаев грибковых поражений респираторного тракта вызваны аспергиллами. Плесневые грибы, провоцирующие развитие болезни, распространены повсеместно. Самое высокое содержание спор аспергилл в окружающей среде отмечается в арабских странах. Их концентрация выше в закрытых помещениях.
Болеют лица, вынужденные контактировать с обсеменённым спорами грибов материалом в силу своей профессиональной деятельности, а также пациенты с иммуносупрессией любого генеза. 20% реципиентов органов и тканей заболевают аспергиллёзом в послеоперационном периоде. У половины из них болезнь приводит к летальному исходу.

Возбудителями болезни являются плесневые грибы рода Aspergillus. Их споры содержатся в воздухе, почве и воде, мицелий активно растет в условиях повышенной влажности. Споры аспергилл устойчивы к высушиванию и длительно сохраняются в частицах пыли. Распространению способствуют мухи, тараканы и другие насекомые. Люди регулярно сталкиваются с патогенами, многие ежедневно вдыхают споры грибов, однако аспергиллёз лёгких развивается у сравнительно небольшой части населения. Факторами риска возникновения патологии являются:
- Иммунодефицитное состояние. Заболеванию подвержены пациенты с нарушением функций иммунитета. Грибковое поражение часто выявляется у лиц с первичным иммунодефицитом, больных СПИДом, онкологическими болезнями, сахарным диабетом. Трансплантация лёгких осложняется микозом у каждого пятого пациента, несколько реже аспергиллёз развивается у реципиентов костного мозга, поджелудочной железы и почек. Возникновению патологического состояния способствует длительный приём антибактериальных препаратов, кортикостероидов и цитостатиков.
- Хроническая патология лёгких. Излюбленными местами локализации аспергиллом являются полостные образования лёгочной ткани, бронхоэктазы. Заболевание часто диагностируют у больных хроническими формами туберкулёза, онкопатологией дыхательной системы, пациентов с муковисцидозом, ХОБЛ.
- Массивная инвазия аспергилл. Заболевают лица с нормально функционирующей иммунной системой, но работающие в условиях массивного обсеменения внешней среды спорами плесневых грибов. В группу риска входят работники мельниц, птицефабрик, пивоварен, фермеры и представители некоторых других профессий. Споры аспергилл в большом количестве могут содержаться в прядильном сырье, системах вентиляции и кондиционирования воздуха, сантехническом оборудовании.
Экзогенный лёгочный аспергиллёз обычно развивается при вдыхании спор грибов. При выраженной имуносупрессии возможна активация сапрофитных аспергилл, обитающих на коже и слизистых оболочках. Происходит аутоинфицирование. Аспергиллы попадают в дыхательную систему. При полноценном клеточном иммунном ответе наблюдается уничтожение и фагоцитоз гифов грибов.
При массивном попадании грибных спор в организм и/или нарушении функций клеточного иммунитета преобладает гуморальный ответ. Образуются гранулёмы, содержащие гифы патогенных грибов – аспергилломы. Они выявляются в бронхоэктазах, туберкулёзных кавернах и других полостях лёгких, на слизистых оболочках трахеи и бронхов. Такая форма болезни является неинвазивной.
Инвазивный аспергиллёз возникает на фоне выраженного иммунодефицита, при значительном снижении уровня гранулоцитов крови. Грибковая инфекция распространяется гематогенным путём, поражает лёгочную паренхиму, плевру, лимфатические узлы. Образуются множественные гранулёмы в различных органах и тканях. Течение болезни приобретает септический характер. Кроме того, некоторые виды аспергилл продуцируют большое количество микотоксинов, другие – являются мощными аллергенами. Развиваются микотоксикозы и аллергические реакции.
Классификация
Существует несколько классификаций лёгочной формы заболевания. По механизму инфицирования различают экзогенный и эндогенный аспергиллёз бронхолёгочной системы. Процесс может протекать остро и хронически. Некоторые специалисты в сфере пульмонологии отдельно выделяют поражение лёгких и дыхательных путей. Рабочая классификация отражает степень инвазии патогенов, их токсические свойства, локализацию процесса, наличие сенсибилизации организма и особенности течения болезни. Она включает:
- Неинвазивный лёгочный аспергиллёз. Возникают единичные и множественные аспергилломы лёгких с относительно доброкачественным течением.
- Инвазивный аспергиллёз респираторного тракта.Инвазивными легочными формами являются изолированный некротический аспергиллёз бронхов, пневмония, плеврит и хроническая лёгочная диссеминация грибковой этиологии.
- Аллергический аспергиллёз бронхов и лёгких. Гиперчувствительность к грибковым аллергенам приводит к развитию аллергического бронхолегочного аспергиллеза - микогенной бронхиальной астмы и экзогенных аллергических альвеолитов.
Симптомы аспергиллёза лёгких
Неинвазивный аспергиллез
Клиническая картина при микотическом поражении респираторных органов зависит от формы патологического процесса. Для неинвазивных аспергиллом характерно бессимптомное течение. Определить длительность инкубационного периода не представляется возможным. Заболевание обнаруживается случайно при прохождении профилактического рентгенологического обследования лёгких. Появление крови в мокроте свидетельствует о прорастании сосудов мицелием грибов и начале инвазивного процесса.
Инвазивный аспергиллез
При вдыхании большого количества патогенов развивается аспергиллёзный трахеобронхит или интерстициальная пневмония. Клиническим проявлениям предшествует короткий – от 1-3 часов до 3 дней – инкубационный период. Появляется стойкое непрекращающееся ощущение горечи во рту, першение в горле. Отмечается повышение температуры до высоких цифр, сопровождающееся ломотой в костях, ознобом. Для аспергиллёзной пневмонии характерна лихорадка неправильного типа. Температура повышается в утренние часы, снижается до нормальных или субфебрильных значений к вечеру.
Заболевание протекает бурно. Кашель в начале болезни мучительный, носит приступообразный характер, позднее становится продуктивным. Отделяется серо-зелёное или кровянистое содержимое бронхов. Больного мучает одышка даже при небольшой нагрузке. Беспокоят интенсивные боли в грудной клетке, усиливающиеся при дыхании и перемене положения тела.
Выражены симптомы общей интоксикации: слабость, потливость, отсутствие аппетита, повышенная утомляемость, похудание. Определяется учащённое сердцебиение и перебои сердечного ритма. Острому инвазивному лёгочному аспергиллёзу часто сопутствует поражение придаточных пазух носа и макулопапулёзные кожные высыпания.
Хронический аспергиллез
При эндогенном инфицировании лёгочный аспергиллёз принимает первично-хроническое течение. Его клинические проявления отличаются от картины интерстициальной пневмонии вялой симптоматикой с длительным субфебрилитетом, незначительным болевым синдромом. Микоз развивается на фоне персистирующего туберкулёза, саркоидоза, ХОБЛ, другой лёгочной патологии и несколько меняет картину основного заболевания. Пациенты обычно отмечают усиление одышки и кашля, обнаруживают серо-зелёные комочки в мокроте.
Аллергический аспергиллез
Аллергический аспергилёз чаще всего протекает в форме тяжёлой гормональнозависимой бронхиальной астмы. Проявляется частыми дневными и ночными приступами удушья, свистящими хрипами и тяжестью в груди, приступами сухого кашля. Больные аллергическим альвеолитом предъявляют жалобы на нарастающую одышку и отхождение небольшого количества слизистой мокроты. Острая форма альвеолита сопровождается признаками общего недомогания, артралгиями.
Осложнения
Своевременная диагностика и правильно выбранная тактика лечения позволяют добиться выздоровления у 25-50% больных респираторным аспергиллёзом. Осложнения возникают при любой форме заболевания. Их частота и тяжесть напрямую зависят от состояния иммунной системы и наличия фоновых патологий. Аспергиллёз утяжеляет течение основного патологического процесса.
У больных с аспергилломами нередко развивается кровохарканье. 25% таких пациентов погибают от лёгочного кровотечения. Острый инвазивный бронхолёгочный аспергилёз при выраженном снижении иммунитета приводит к возникновению микогенного сепсиса с высокой (50%) летальностью. Хроническое течение осложняется сердечно-легочной недостаточностью и последующей инвалидизацией больного.
Пациенты с лёгочными проявлениями аспергилёза обследуются у пульмонолога. При сборе анамнеза уточняется профессия, наличие хронической бронхолёгочной патологии, первичного или вторичного иммунодефицита. При осмотре и физикальном исследовании выявляются разнообразные неспецифичные симптомы. При аспергиллёзной пневмонии выслушиваются распространённые сухие и влажные мелкопузырчатые хрипы. В остальных случаях аускультативные данные обычно бывают скудными или отражают течение фонового процесса. Основными методами диагностики являются:
- Лучевая диагностика.Рентгенологическая картина в легких отличается разнообразием. Определяются нестойкие эозинофильные инфильтраты, плотные округлые или шаровидные тени с полостями распада, расположенные преимущественно в верхних долях лёгких, мелкоочаговая диссеминация. Характерным признаком аспергилломы является наличие серповидного просветления в полости округлого или овального образования, которое смещается при изменении положения тела (симптом погремушки). При заполнении полости аспергилломы контрастом грибные массы всплывают (симптом поплавка).
- Лабораторные исследования. В общеклиническом анализе крови отмечается лейкоцитоз, эозинофилия, повышение СОЭ. При микроскопии мокроты, промывных вод бронхов обнаруживаются грибные гифы. Культуральный метод позволяет вырастить колонии аспергилл на питательных средах. С помощью серологических реакций (ИФА, РСК) выявляются антитела к плесневым грибкам. Для пациентов с аллергической формой болезни характерен подъём уровня общего IgЕ. При хроническом аспергилёзе повышается IgG.
- Бронхоскопия. При эндоскопии бронхов определяется деформация трахеобронхиального дерева, признаки катарального воспаления слизистой оболочки бронхов. При попадании бронхоскопа в аспергиллому обнаруживается пушистый налёт серо-жёлтого или зеленоватого цвета, с трудом отделяющийся от стенок полости. Выполняется микроскопия и культуральное исследование полученного патологического материала.
Лёгочный аспергилёз необходимо дифференцировать с заболеваниями опухолевой природы, туберкулёзом, саркоидозом, деструктивной пневмонией другой этиологии. В последнее время микоз часто утяжеляет течение вышеуказанной патологии, поэтому в диагностическом поиске нередко принимают участие фтизиатры и онкологи. Из-за частого поражения патогенами ЛОР-органов все пациенты с подозрением на аспергиллёз направляются на консультацию к оториноларингологу.

КТ ОГК. Полостное объемное образование в нижней доле правого легкого, частично заполненное грибковыми массами.
Лечение аспергиллёза лёгких
Длительность терапии и объём лечебных мероприятий зависят от формы заболевания и состояния иммунитета больного. Аспергиллёз бронхов, нетяжёлая микотическая пневмония у иммунокомпетентных лиц излечиваются за 7-10 дней в амбулаторных условиях. Показаниями к госпитализации являются кровохарканье, длительный эпизод фебрильной лихорадки, затяжной приступный период бронхиальной астмы. Основной группой препаратов, применяющихся для лечения данной патологии, являются с активные в отношении аспергилл антифунгальные средства.
Параллельно осуществляется медикаментозная терапия фонового процесса. Используются антибактериальные препараты и кортикостероидные гормоны. Питание больных аспергиллёзом должно быть полноценным, сбалансированным, высококалорийным. Аспергилломы, сопровождающиеся кровохарканьем, подлежат хирургическому удалению. Выполняется резекция лёгкого или лобэктомия. При выраженной дыхательной недостаточности для профилактики кровотечения в качестве временной меры применяется перевязка соответствующей бронхиальной артерии.
При лёгких формах аспергиллёза прогноз благоприятный, наступает полное выздоровление. Хронизация процесса приводит к формированию лёгочного сердца и инвалидности. Выраженный иммунодефицит может способствовать генерализации микоза и закончиться смертью больного. В качестве профилактики лица из групп профессионального риска должны использовать индивидуальные средства защиты и проходить регулярные профилактические осмотры. Пациенты с выраженными нарушениями функций иммунной системы подлежат рациональному трудоустройству и регулярному серологическому обследованию на аспергиллёз. Им запрещается употреблять в пищу продукты с плесенью, долго находиться в сырых и пыльных помещениях.
1. Аспергиллез легких: клинические формы, диагностика, лечение/ Гаврисюк В.К., Кривец В.А.//Украинский пульмонологический журнал – 2015 - №4.
2. Обзор рекомендаций американского общества по инфекционным болезням по лечению аспергиллеза/ Масчан А.А., Клясова Г.А., Веселов А.В.// Клиническая Микробиология и Антимикробная Химиотерапия. – 2008 – Т10, № 2.
3. Клинико-иммунологические особенности неинвазивного аспергиллеза легких: Автореферат диссертации/ Павленко Т.Г. – 2008.
Легочная эозинофилия. Причины и классификация легочной эозинофилии
Избыток эозинофилов в крови, тканях или мокроте может наблюдаться при самых разнообразных заболеваниях легких. Действительно, время от времени публикуются отдельные случаи, в которых эозинофилия была обнаружена в сочетании почти с каждым из существующих видов легочной патологии. В настоящей главе мы разберем синдромы, для которых типично сочетание эозинофилии крови и патологии легких, т. е. измененной рентгенограммы грудной клетки.
Согласно традиционному смыслу, легочная эозинофилия означает синдромы, характеризуемые преходящими тенями на рентгенограммах грудной клетки вместе с эозинофилией крови. Часто имеется также эозинофилия мокроты как косвенное проявление тканевой эозинофилии. Это определение вполне подходит для острых случаев, однако сейчас известно, что нередко, особенно при бронхолегочном аспергиллезе и некоторых медикаментозных реакциях, возможны более хронические изменения и па рентгенограммах имеются постоянные отклонения от нормы. Мы будем обсуждать и эти синдромы.
Crofton и соавт. (1952) перечислили некоторые из многочисленных причин легочной эозинофилии, обсудили их разнообразные клинические признаки у 16 больных, а также рассмотрели еще 450 случаев, описанных в литературе, появившейся к тому времени. Reeder и Goodrich (1952) в США описали синдром ЛИЭ (легочная инфильтрация с эозипофилией) у 4 больных и отметили, что в ряде случаев этиологический агент не удается распознать, a Lift (1969) опубликовал обзор на эту тему. Hinson и соавт. (1952) указывали, что важной причиной синдрома может быть A. fumigatus.

Ввиду выраженных изменений как альвеол, так и бронхиальной стенки появился широко распространенный и правильный термин «бронхолегочный аспергиллез» [Hinson et al., 1952; Handerson, 1.968; McCarthy, Pepys, 1971]. Corrington и соавт. (1969) рассматривают патологические изменения при хронической эозинофилыюй пневмонии.
Клиническая классификация легочных эозинофилий: легочная эозинофилия при астме и без астмы. Эта классификация подчеркивает два момента: во-первых, легочная эозинофилия встречается при астме и без нее, и, во-вторых, в обеих группах насчитывается ряд известных и весьма разнообразных причин экзогенной легочной эози-нофилии (например, гельминты, грибы, особенно A. fumigatus и медикаменты).
Напротив, криптогенная легочная эозинофилия [McCarthy, Pepys, 1973; Turner-Warwick et al., 1976] может иметь место как при астме, так и без нее, но согласно самому ее определению причины установить невозможно. Однако теперь в этой категории были открыты некоторые важные иммунологические особенности.
Информация на сайте подлежит консультации лечащим врачом и не заменяет очной консультации с ним.
См. подробнее в пользовательском соглашении.
Эозинофилия
Эозинофилия (эозинофильный лейкоцитоз) – это увеличение в крови уровня эозинофилов больше 500 в 1 мкл крови или больше 5%. Чаще всего встречается при аллергических реакциях, паразитарных инвазиях, может свидетельствовать о тяжелых заболеваниях легких, онкологических гематологических патологиях. Специфических проявлений нет. Клиническая картина зависит от заболевания, при котором наблюдается повышенное содержание эозинофилов. Уровень эозинофилов исследуется в венозной или капиллярной крови путем подсчета лейкоцитарной формулы в общем анализе крови. Для коррекции эозинофилии необходимо лечение заболевания, которое ее вызвало.
На сегодняшний день существуют две основные классификации эозинофилии – по уровню повышения эозинофилов и по этиопатогенетическому фактору. По количеству клеток различают следующие эозинофилии:
- Легкие. Уровень эозинофилов от 500 до 1500.
- Умеренные. Концентрация эозинофилов от 1500 до 5000.
- Выраженные. Содержание эозинофилов составляет более 5000. Наиболее характерны для гельминтозов, гематологических болезней.
Умеренные и выраженные эозинофилии объединяют термином гиперэозинофилии. По патофизиологическому механизму эозинофилии разделяют на:
- Клональные. Эозинофилы являются частью злокачественного клона. Встречаются при миелопролиферативных гемобластозах (лейкозах), системных заболеваниях тучных клеток (мастоцитозе).
- Реактивные. Общий механизм возникновения – гиперпродукция Т-хелперами интерлейкина-5, который стимулирует костномозговую выработку эозинофилов. Развиваются как ответная реакция на различные внешние воздействия на макроорганизм – аллергены, паразитарные инвазии и т.д. Составляют около 90% всех эозинофилий.
Отдельно выделяют транзиторную (кратковременную) эозинофилию, не связанную напрямую с конкретными заболеваниями. Количество эозинофилов может увеличиться при употреблении некоторых лекарственных препаратов (антибиотиков, противотуберкулезных средств), введении вакцины против гепатита А, при проведении гемодиализа, воздействии локальной радиационной терапии. Точный патофизиологических механизм повышения эозинофилов при этих обстоятельствах неизвестен.
Причины эозинофилии
Аллергии
Это наиболее частая причина эозинофилии. Любые реакции гиперчувствительности сопровождаются увеличением продукции эозинофилов костным мозгом. Патогенез эозинофилий при аллергиях хорошо изучен. При попадании в организм аллергена (ингаляционно, через кожу или слизистые) он взаимодействует с IgE на мембране базофилов. Это приводит к их дегрануляции последних и высвобождению гистамина, лейкотриенов и других медиаторов, в результате чего в тканях развивается аллергическое воспаление, что и обусловливает симптоматику со стороны кожи (атопический дерматит, крапивница), слизистых оболочек (аллергический ринит, конъюнктивит), а также дыхательной системы (бронхиальная астма).
Параллельно с этим базофилами выделяется эозинофильный хемотаксический фактор анафилаксии, который стимулирует миграцию эозинофилов из периферической крови к очагу воспаления. Эозинофилы, в свою очередь, подавляют выработку медиаторов аллергии. Во время разгара аллергической реакции (обострения) уровень эозинофилии максимальный; по мере разрешения симптомов он постепенно снижается и нормализуется в стадию ремиссии.
При выраженном обострении содержание эозинофилов, наоборот, может быть снижено (эозинопения) или даже равно нулю (анэозинофилия). Такое случается, когда произошла массивная миграция эозинофилов к очагу аллергического воспаления, а новые эозинофилы еще не успели синтезироваться в костном мозге. Также, если во время рецидива бронхиальной астмы присоединится вторичная бактериальная инфекция (бронхит), то показатели эозинофилов могут оставаться в пределах нормы.
В основном при аллергиях встречается легкая степень эозинофилии. Для бронхиальной астмы, особенно атопической и аспириновой формы, характерна умеренная эозинофилия. При аллергических патологиях повышенное содержание эозинофилов наблюдается не только в крови, но и в других биологических жидкостях (в мокроте и бронхоальвеолярной жидкости – при бронхиальной астме, в носовой слизи – при рините, в соскобе с конъюнктивы – при конъюнктивите).
Гельминтозы
Другой частой причиной эозинофилий (особенно среди детей) является заражение гельминтами. Эозинофилия в данном случае обусловлена двумя патогенетическими механизмами. Во-первых, эозинофилы обладают противопаразитарной активностью – они выделяют эозинофильный катионный белок и активные формы кислорода, которые губительны для гельминтов. Во-вторых, продукты метаболизма гельминтов способны индуцировать реакции гиперчувствительности. Именно поэтому глистные инвазии часто сопровождаются аллергической симптоматикой.
Самые частые гельминтозы, сопряженные с высокой эозинофилией среди детей – аскаридоз, токсокароз, среди взрослых ‒ анкилостомидоз, описторхоз. При стронгилоидозе эозинофильный лейкоцитоз долгое время может быть единственным проявлением. Эозинофилия выявляется уже на 4-5 день инфицирования. Затем она очень быстро нарастает и достигает максимума примерно к 30-40 дню, а потом медленно начинает уменьшаться, но продолжает оставаться на высоких цифрах длительное время. Уровень эозинофилов очень большой (может составлять от 20% до 70-80%). Резкое нарастание эозинофилии происходит во время стадии миграции личинок по организму и проникновения в ткани.
Заболевания легких
Существует группа болезней легких, называемых легочными эозинофилиями, которые объединяет большое содержание эозинофилов в крови, в бронхоальвеолярной жидкости и образование эозинофильных инфильтратов в легочной ткани. Точный патогенез эозинофилии периферической крови и инфильтрации эозинофилами легочной ткани при большинстве этих заболеваний неизвестен. Различают следующие легочные эозинофилии:
- Эозинофильные пневмонии. К ним относятся синдром Леффлера (простая легочная эозинофилия), острые, хронические эозинофильные пневмонии (ОЭП, ХЭП). При синдроме Леффлера наблюдается легкая эозинофилия, которая быстро и самостоятельно разрешается. Для ХЭП характерен постоянный умеренный эозинофильный лейкоцитоз. При ОЭП отмечается эозинофилия, резко нарастающая до высоких цифр (до 25%) и столь же стремительно регрессирующая на фоне терапии глюкокортикостероидами.
- Аллергический бронхолегочный аспергиллез. Обусловлен гиперчувствительностью больных к грибкам рода аспергилл. Патогенез сходен с аллергическими патологиями (IgE-опосредованная реакция). Эозинофилия умеренная, возникает только в фазу обострения. В период ремиссии уровень эозинофилов находится пределах нормальных значений.
- Синдром Черджа-Стросса. Эозинофильный гранулематоз с полиангиитом ‒ тяжелое заболевание неизвестной этиологии из ряда системных васкулитов, поражающее несколько внутренних органов. Эозинофильный лейкоцитоз наиболее высокий среди всех легочных эозинофилий, в период рецидива может доходить до 50%.

Болезни крови
Во время некоторых злокачественных гематологических заболеваний в крови наблюдается повышенный уровень эозинофилов с разным патогенетическим механизмом. При миелопролиферативных патологиях (остром и хроническом эозинофильном лейкозе, хроническом миелолейкозе), агрессивном системном мастоцитозе эозинофилия обусловлена опухолевой (клональной) пролиферацией эозинофильного ростка кроветворения.
Эозинофилия нарастает медленно, в течение нескольких лет. При мастоцитозе достигает умеренных значений, при лейкозах – выраженных (до 60-70%). Уменьшается очень медленно, под действием химиотерапии. Кроме периферической крови, эозинофилия наблюдается также в миелограмме (мазке пунктата костного мозга). Для лейкозов существует специфичный лабораторный признак ‒ одновременное увеличение эозинофилов и базофилов (базофильно-эозинофильная ассоциация).
При лимфогранулематозе и неходжкинских лимфомах эозинофилия возникает вследствие продуцирования лимфатическими клетками цитокинов (в том числе интерлейкин-5), которые стимулируют пролиферацию нормальных эозинофилов. Эозинофильный лейкоцитоз умеренный, медленно нарастающий.
Заболевания ЖКТ
Эозинофилия сопровождает некоторые болезни органов пищеварения. К ним относят эозинофильный эзофагит, гастрит и энтероколит. Морфологическим субстратом является инфильтрация эозинофилами стенок пищевода, желудка, кишечника. Патогенез до сих пор остается предметом дискуссий.
Предполагается, что у наследственно предрасположенных лиц воздействие пищевых аллергенов на слизистую оболочку вызывает активацию антиген-презентирующих клеток (Т-лимфоцитов), вырабатывающих интерлейкины и эотаксин-3. В результате этого происходит миграция эозинофилов и инфильтрация ими слизистой оболочки органов ЖКТ. Эозинофильный лейкоцитоз обычно легкий и наблюдается только во время выраженного обострения заболевания. Высокая концентрация эозинофилов в биоптате слизистых, напротив, встречается постоянно.
Эндокринопатии
Некоторые гормоны, например, глюкокортикостероиды (гормоны коры надпочечников), стимулируют апоптоз (запрограммированную клеточную гибель) эозинофилов. Поэтому заболеваниям, сопровождающимся снижением уровня глюкокортикостероидов, сопутствует эозинофилия. К таким патологиям относятся первичная надпочечниковая недостаточность (болезнь Аддисона), врожденная дисфункция коры надпочечников, а также множественные эндокринопатии, такие как синдром Шмидта, пангипопитуитаризм. Степень эозинофилии легкая. Количество эозинофилов быстро нормализуется после введения глюкокортикоидов.
Иммунодефицитные состояния
Эозинофилия встречается при, так называемых, первичных иммунодефицитах – тяжелых болезнях с высокой летальностью, обусловленных генетическим дефектом одного или нескольких компонентов иммунной системы (клеточных, гуморальных реакций, фагоцитоза и пр.). Такими заболеваниями являются синдром Вискотта-Олдрича и синдром Джоба (гипер-IgE-синдром). Эозинофилия, вероятно, связана с аномальной гиперпродукцией иммуноглобулина Е. Уровень эозинофилов в тканях и крови очень высокий (до 60%), не поддается коррекции.
Злокачественные новообразования
Некоторые опухоли, особенно аденокарциномы легких, органов пищеварительной и мочеполовой системы, имеют способность к выработке эозинофильного хемотаксического фактора, стимулирующего костномозговую продукцию эозинофилов. При таких заболеваниях эозинофильный лейкоцитоз нарастает медленно, достигает высоких значений (до 20-40%). Концентрация эозинофилов периферической крови возвращается к норме после долгой химиотерапии или хирургического удаления злокачественного образования.
Эозинофилия выявляется при подсчете лейкоцитарной формулы клинического анализа крови. Так как спектр патологий, сопровождающихся эозинофилией, довольно широк, при впервые выявленных изменениях в анализах необходимо обратиться к врачу-терапевту. Для подтверждения заболевания, вызвавшего эозинофилию, с учетом клинических и анамнестических данных назначается обследование, которое может включать:
- Анализы крови. Определяется уровень эритроцитов, лейкоцитов, тромбоцитов. Проверяется наличие специфических антител к гельминтам, грибкам, антицитоплазматических антител (ANCA), концентрация некоторых гормонов (кортизола, паратгормона, эстрогенов, андрогенов). Проводится генетическое исследование на первичные иммунодефициты, а также иммунофенотипирование, иммуногистохимический анализ клеток крови для обнаружения специфических опухолевых антигенов (CD-маркеров).
- Аллергодиагностика. Для выявления аллергена выполняются различные аллергопробы – кожные (скарификационные, аппликационные, прик-тесты), провокационные (назальные, ингаляционные, конъюнктивальные), прямой и непрямой базофильный тесты. Методом ИФА измеряется уровень иммуноглобулина E (IgE).
- Исследование мокроты. Осуществляется микроскопическое исследование мокроты для изучения клеточного состава (количества эозинофилов, наличия кристаллов Шарко-Лейдена, спиралей Куршмана), выявления личинок гельминтов. Проводится бактериологический, микологический посев мокроты с определением чувствительности к антибактериальным и противогрибковым препаратам.
- Рентгенологические исследования. Одним из наиболее информативных методов диагностики легочных эозинофилий считается рентгенография грудной клетки. На снимках обнаруживаются летучие (мигрирующие) эозинофильные инфильтраты в виде участков затемнения. При аллергическом бронхолегочном аспергиллезе могут быть видны бронхоэктазы, фиброз верхних отделов легких.
- Эндоскопия. При подозрении на эозинофильное поражение органов желудочно-кишечного тракта проводятся фиброгастродуоденоскопия и фиброколоноскопия со взятием биопсийного материала. Для морфологической картины, помимо эозинофильной инфильтрации, характерен фиброз собственной пластинки слизистой оболочки.
- Спирометрия. При поражении дыхательной системы выполняется оценка функции внешнего дыхания. Измеряется степень проходимости бронхов мелкого и среднего калибра, растяжимость легочной ткани. Для пациентов с бронхиальной астмой типично уменьшение объема выдыхаемого воздуха (индекс Тиффно) и улучшение дыхательной функции после фармакологической пробы с сальбутамолом. При легочных эозинофилиях наблюдается снижение жизненной емкости легких.
- Гистология. С целью подтверждения синдрома Черджа-Стросса берется биопсия легкого. Отмечаются периваскулярные эозинофильные инфильтраты. Для изучения морфологической картины костного мозга (в случае подозрения на лейкоз) прибегают к стернальной пункции и трепанобиопсии. Обнаруживаются гиперплазия гранулоцитарного ростка кроветворения, гиперклеточность за счет эозинофильных миелобластов.
Коррекция
Самостоятельная коррекция эозинофилии невозможна. Для нормализации уровня эозинофилов необходимо бороться с причиной. Если эозинофилия легкая, связана с приемом ЛС или вакцинацией либо приходится на период реконвалесценции – беспокоиться не стоит. Нужно понаблюдать кровь в динамике через 7-10 дней. При обнаружении стойкой или высокой эозинофилии в анализе крови следует обратиться к специалисту, чтобы тот на основании осмотра, жалоб, анамнеза провел диагностический поиск этиологического фактора и назначил соответствующее лечение. Для терапии большинства болезней, сопровождающихся эозинофилией, используются лекарственные препараты из группы антигистаминных средств или глюкокортикостероидов.
Прогноз
Только по одному лишь эозинофильному лейкоцитозу в крови невозможно предсказать риск возникновения тех или иных последствий для здоровья и жизни человека. Прогноз всегда определяется основным заболеванием и своевременностью его диагностирования – он может варьироваться от благоприятного при аллергическом конъюнктивите до высокой вероятности летального исхода при злокачественных новообразованиях или миелопролиферативных патологиях. Поэтому любое превышение референсных значений эозинофилов в клиническом анализе крови требует тщательного обследования для установления причины.
2. Дифференциальный диагноз внутренних болезней: Алгоритмический подход/ Хили П.М., Джекобсон Э.Дж. - 2014.
4. Синдромная диагностика и базисная фармакология заболеваний внутренних органов. В 2 томах, т. 2/ под ред. Г.Б. Федосеева, Ю.Д. Игнатова. – 2004.
Эозинофилия - лечение в Москве
Комментарии к статье
Да, интересно пришли к адекватному результату. У нас врачи даже особо не заинтересовались этой патологией-я поняла, что найти истинную причину очень сложно-почти что пальцем в небо. Или лечить одновременно все возможные причинные направления.
Читайте также:
- Отравление цианидами на МРТ головного мозга
- Опухоли слюнных желез - причины, распространенность
- Рентгенограмма, МРТ при повреждении кольцевой связки локтевого сустава
- Кариес. Причины кариеса. Классификация кариеса.
- Избыточная продукция тиреоидных гормонов. Гипертиреоза. Кретинизм. Гипотиреоз. Микседема. Тиреоидная недостаточность.
